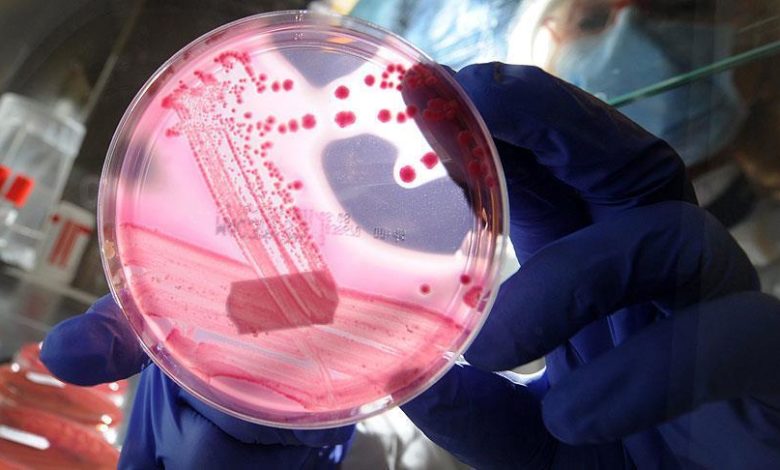

Ülkemizde ölümlerin ikinci büyük nedeni olan kanserlerden genlerimize uygun yaşayarak korunmak mümkün. Genlerden yola çıkılarak hazırlanan koruyucu tıp uygulamaları ile her üç kanser vakasından ikisi önlenebilir.
Kardiyovasküler hastalıklardan sonra ikinci en sık ölüm sebebi olan kanserler, genetik, yaşam tarzı ve çevresel faktörlerin bir araya gelmesiyle oluşuyor. Kanserlerde genetik yatkınlık, hastalık ortaya çıkmadan bilinirse, başta beslenme olmak üzere yaşam tarzı düzenlemeleri ile hastalığın ortaya çıkması tamamen engellenebilir veya geciktirilebilir.
Tıp dünyası, geçtiğimiz yıllarda sadece çevresel faktörlerin neden olduğu hastalıklara müdahale edilebiliyorken, günümüz teknolojisinde genetik yatkınlıklar ve yaşam faktörlerinin birleşmesi ile ortaya çıkan kanser gibi rahatsızlıklara karşı erken tedbir alabiliyor.
2030 yılına kadar kanserin görülme sıklığında tüm dünyada iki misline yakın bir artış öngörülüyor. Bu bağlamda kanserle mücadele için koruyucu ve önleyici hekimliğin yayılması gerekiyor.
Bir çok kanser türünden basit yöntemlerle korunmak mümkündür. Asıl mesele kimin hangi önlemi alması gerektiğidir. Birçok insan sigara içer, bazıları kanser olur. Kimi insan günde iki paket sigara içer fakat kanser olmaz.
Bunun nedeni bireyin akciğer kanserine olan genetik yatkınlığıdır. En sık görülen meme, prostat, kalın bağırsak, mide ve cilt kanserlerinde de aynı durum geçerlidir. Bu kanser türlerinden genetik yatkınlığımıza göre farklı önlemler alarak korunabiliriz.
Elbette sigara içmemek gibi genel bir öneri herkes için geçerlidir fakat oksidatif stres, yetersiz detoks, DNA kırıklarının tamir edilememesi gibi kişiden kişiye farklılık gösteren yatkınlıkların da kontrol altına alınması gerekir.
Bu çalışma yapılırken kişiden kişiye farklılık gösterecek önlemler alınmalıdır. Bireyin kansere yol açan genetik yatkınlıkları tespit edilerek bunlar doğrultusunda kişiye özel uygun yaşam tarzı planı geliştirilir ve sürdürülürse, her üç kanser vakasından ikisi önlenebilir.
Tıp biliminde sessiz bir devrim başlatan koruyucu genetik çalışmaları neticesinde sadece kanserler değil; kalp krizi, inme, diyabet, obezite, Alzheimer hastalığı ve kemik erimesi gibi pek çok kompleks hastalıktan korunmak mümkün.